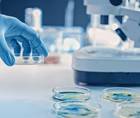

advertisement
Allergy, Asthma, and Immunology
81-96 of 240
ajmc.com
07/16/2024- Medical NewsResearch Suggests Early Life Antibiotic Increases Asthma Risk, Providing Clues to Potential Prevention of Adult Asthma
medicalxpress.com
07/16/2024
hopkinsmedicine.org
07/12/2024
medicalxpress.com
07/11/2024
cancer.gov
07/11/2024- Medical NewsCould a Dietary Fiber Supplement Offer Long-Awaited Treatment for Food Allergy Sufferers?
news.umich.edu
07/10/2024
medicalxpress.com
07/09/2024- Medical NewsStates with Highest COVID-19 Vaccination Rates Showed Steepest Decline in Pediatric Asthma Prevalence
prnewswire.com
07/05/2024
eurekalert.org
07/03/2024- Medical NewsStudy Suggests Regular Vaccine Boosts May Help People Who Are Immunocompromised Fight COVID-19
hopkinsmedicine.org
07/03/2024 - Medical NewsSerum Eosinophil-Derived Neurotoxin: A New Promising Biomarker for Cow’s Milk Allergy Diagnosis
nature.com
07/03/2024
nih.gov
06/28/2024
sanger.ac.uk
06/21/2024- Medical NewsNew Study Involving Nearly 185,000 Patients Recommends Strengthening Immunity Against COVID-19 in People with Cancer
medicalxpress.com
06/20/2024 - Medical NewsDiscovery of ‘New Rules of the Immune System’ Could Improve Treatment of Inflammatory Diseases, Say Scientists
cam.ac.uk
06/19/2024
news.uga.edu
06/18/2024